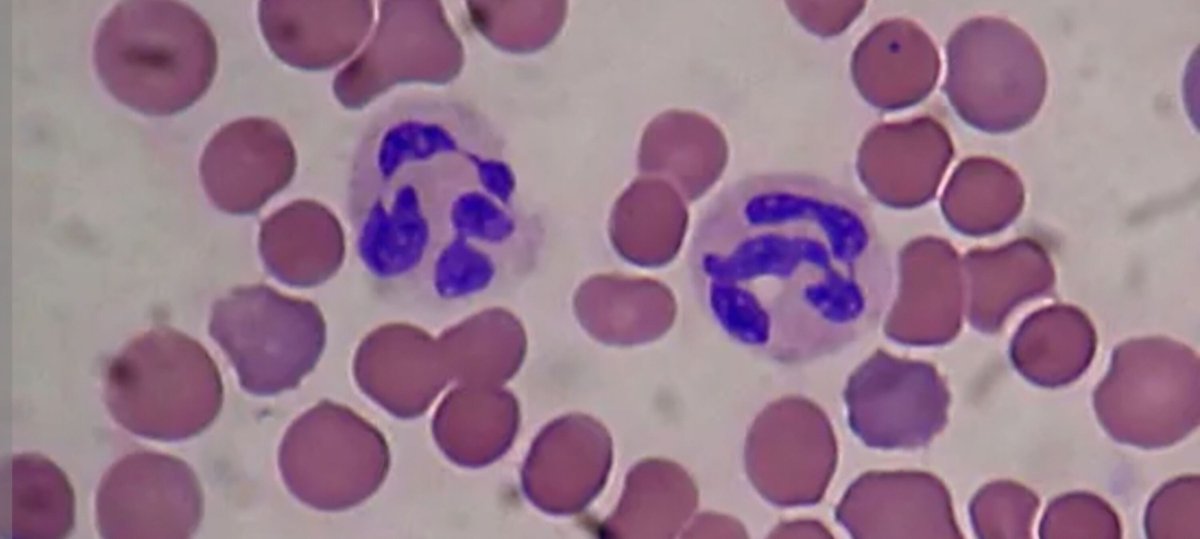
sjcrmain's tweet image. Impressive concentration at our Prep STEM Club last night! Look at these amazing white blood cell drawings under the microscope! 🧬✨ 

#STEMKids #FutureScientists #MicroscopyMagic #LearningThroughPlay

#stemkids search results
Robots collaborating today shape industries tomorrow. Help your child learn robotics and innovation. Book a free trial with Moonpreneur: tinyurl.com/nhttuspm #FutureInnovators #STEMKids #Moonpreneur
🌧️ Rainy days are perfect for hands-on learning @OMSI 🦖✨ 🐋 Research supports that visiting museums at an early age helps in developing higher critical and creative thinking skills, which are essential for future success. #stemkids #sciencemuseum #portlandadventures #stem
🤖 NEW: "Scout to the Rescue" - the first children's book teaching real AI concepts through storytelling! Your kid's future is AI. Start their education today! lulu.com/shop/husam-yag… #AIEducation #STEMKids
Explore the basic principles of flight, ride a hovercraft, build airplanes, and construct balloon copters! This hands-on Mad Science program teaches you all about aerodynamics and the world above us! #MadScience #MadScienceBayArea #STEMkids #Fremont #FremontCamp

Turn imagination into real creations 🧠✨ Kids design, create, and explore the world of 3D modeling and innovation. 🚀 Enroll now and let your child build the future! #3DDesign #STEMKids #FutureCreators #TechForKids #CreativeLearning #SummerCamp #Innovation #DigitalSkills

🚨 FLASH SALE / PROMO! 🚨 Ready to turn your gamer into a coder? Use code CODEKIDS for 10% off your copy of Upper Elementary Programming this weekend only! Shop here: 🛒💻 ndwtech.org/techforeveryon… #CodingForKids #STEMKids #EdTech #PythonForKids

Squash weekend boredom with fun projects, like gooey oobleck and Diet Coke-Mento geysers! #BoredomBusters #STEMKids #WeekendFun blog.txfb-ins.com/texas-living/e…
blog.txfb-ins.com
5 Science Experiments Kids Can Do at Home | Texas Heritage for Living
Little experiments for little scientists.
Sound creates visible structure. Cymatics is physics made real. The engineers decoding this are students today. Is your child building toward that future? tinyurl.com/bde7aukt #Cymatics #Moonpreneur #STEMKids
Coding helps kids develop critical thinking skills & give them one of the most profitable skills to learn (plus, they're faster at learning than adults😅) #STEMkids

🎵 Young Innovator in Action! 🎵 Meet Keerthan, a talented young mind from Brainy n Bright, who turned creativity into innovation! A big round of applause for this brilliant effort and passion for learning! 👏✨ #youngcoder #innovation #stemkids #brainyandbright
Be part of the Math Kangaroo family 🦘 Don’t wait! Register today: mathkangaroo.org/mks/registrati… and give your child a fun math challenge! ✨ See our 2025 Annual Highlights and join the adventure. mathkangaroo.org/mks/resources/… #MathKangaroo #STEMKids #MathEducation #MathFun #MathCommunity
🌿 Outdoor science fun! Our Early Head Start cuties took learning outside to explore leaves—comparing sizes, shapes, and their unique textures. Hands-on learning at its cutest! 🍃✨ @natlheadstart #EarlyHeadStart #OutdoorLearning #STEMkids #NatureExplorers




🎨☀️ Every brushstroke tells a story, and every child is an artist! This #WorldArtDay, let’s inspire kids to create, explore, and imagine—while learning through fun, hands-on STEM and solar activities. 🌈⚡ #GoSolarKidz #STEMKids #CreativeLearning #FutureInnovators

Roller coaster day! 🎢 Students learned about gravity & energy, then designed and built their own creative paper roller coasters. #STEMKids #EngineeringFun #FutureEngineers



Thought it was just a weekend activity… turned out to be their favorite class 🤯 One session in and they didn’t want to leave. Building, focusing, and actually finishing something—pure joy. 💡 Rare to find a class that’s fun, engaging, AND productive 📍 Oakville #STEMkids
Float or sink? 🤔💧 Our curious first graders turned into little scientists today! They made predictions, tested their hypotheses, and recorded their results — all while having a great time in the lab! 🔬📓 #ScienceDay #FirstGradeExperiments #STEMKids #SinkOrFloat




Lights + Legos = STEM magic at Fort Tryon JCC! 🤖✨ Students coded blinking lights, built Lego vehicles, and leveled up their word block programming skills. So proud of their creativity and growth! 💡💻💕 #STEMkids #CodingForKids #FutureInnovators #HandsOnLearning #LEGO #STEM



🌋 ERUPTION ALERT! Year 4 used #5DThinking to EXPLODE into geology: 🔍 Discover → 📌 Define → ✏️ Design → 🧠 Develop → 💥 Deliver! Watch our vinegar + baking soda volcano blow minds (safely!). #ScienceRocks #STEMkids #PrimaryEd #HandsOnScience #VolcanoDay

🚨 Triad parents! We still have spots open for Mad Science camps at Salem Montessori (Winston-Salem) 🧪 Hands-on experiments, take-home projects & tons of fun! Spots are LOW—don’t miss out! 👉 zurl.co/KqHe8 #TriadNC #STEMKids #SummerCamps

Thought it was just a weekend activity… turned out to be their favorite class 🤯 One session in and they didn’t want to leave. Building, focusing, and actually finishing something—pure joy. 💡 Rare to find a class that’s fun, engaging, AND productive 📍 Oakville #STEMkids
Turn imagination into real creations 🧠✨ Kids design, create, and explore the world of 3D modeling and innovation. 🚀 Enroll now and let your child build the future! #3DDesign #STEMKids #FutureCreators #TechForKids #CreativeLearning #SummerCamp #Innovation #DigitalSkills

🎵 Young Innovator in Action! 🎵 Meet Keerthan, a talented young mind from Brainy n Bright, who turned creativity into innovation! A big round of applause for this brilliant effort and passion for learning! 👏✨ #youngcoder #innovation #stemkids #brainyandbright
🎨☀️ Every brushstroke tells a story, and every child is an artist! This #WorldArtDay, let’s inspire kids to create, explore, and imagine—while learning through fun, hands-on STEM and solar activities. 🌈⚡ #GoSolarKidz #STEMKids #CreativeLearning #FutureInnovators

🚨 FLASH SALE / PROMO! 🚨 Ready to turn your gamer into a coder? Use code CODEKIDS for 10% off your copy of Upper Elementary Programming this weekend only! Shop here: 🛒💻 ndwtech.org/techforeveryon… #CodingForKids #STEMKids #EdTech #PythonForKids

MicroCam-X1 4K Digital Camera 📸🔬 12MP BSI CMOS Sensor • 400X Microscope for STEM Learning & 4K Video with Autofocus 3.5" LCD Screen • Compact, Portable Point & Shoot Design Ideal for Travel & Kids’ Gifts 🔗👉 amzn.to/4mo8HD2 #STEMKids #GiftIdeas #TechToys #4KCamera

Other parents already signed their kids up for coding this vacation… and yours? 😬 2 weeks of fun coding, creativity & problem-solving for ages 7–10. Register now 👉 bit.ly/AlgoPeersVacat… 📞 0545109600 | 0539875780 | 0508694728 #codingclasses #STEMkids


🌙✨ Meet the girl whose love for numbers helped land humans on the moon! 🚀 Margaret and the Moon inspires future coders + dreamers. 🔗 bytemeastory.com/book-links/mar… Author: @deanrobbins ✍️ Shared by @bytemeastory ✨ #WomenOfNASA #STEMKids #Book #ChildrensBooks #NASAHistory #NASA

Impatient to grow up Meet Nico the dragonfly nymph in a heartwarming kids story that blends real science with a powerful message about patience growth and self confidence Perfect for ages 4 to 8. #ChildrensBooks #STEMkids #PictureBook #Nature #Dragonfly amzn.to/4t3Yuhv

🤖🔬Our AI Voice Electronic Scientific Circuit Experiment is the ultimate STEM adventure! 🧠 Watch it come to life at The Little Tots Store! 📟🧪🎟️ Code: springin26 (20% OFF!) 💸 $74.88 – $169.88 📲thelittletotsstore.com/.../ai-voice-e… #TheLittleTotsStore #STEMKids #ScienceIsCool #Caturday


You might be missing something in life... Take a look! 👀 #MatataStudio #STEMeducation #STEMkids #STEAM #CodingAdventure #LearnThroughPlay
🚀Space is having a moment! With #ArtemisII heading around the Moon, it’s the perfect time to spark kids’ curiosity. Check out the Best Space Books for Kids. Fun, inspiring, and out of this world!👉bit.ly/41thbPI #STEMKids #KidsBooks #SpaceForKids #FutureAstronauts

Drilling through solid rock — faster, with less wear. A water jet built into the drill bit cuts heat and friction at the contact point. The engineers advancing this are students today. Is your child one of them? tinyurl.com/mr3twvdx #TunnelEngineering #Moonpreneur #STEMKids
Heat destroys drill bits in hard rock. A water jet built into the bit fixes it — cooler contact, less friction, faster tunnels. The students advancing this start now. Moonpreneur builds that foundation. shorturl.at/L3YoV #TunnelEngineering #Moonpreneur #STEMKids
🚀 Future astronauts, this is your mission! Kids will build rockets, explore planets, & train like real space explorers in our NASA-inspired club 👩🚀 📍 Thales Holly Springs 📅 Starts April 16 ⏳ Spots limited! 🔗 zurl.co/TqhiU #STEMkids #AfterSchoolClub

48 hours. A full house. Factory precision meets on-site assembly. No weather delays. No errors. Construction that finally scales like manufacturing. The students building this start now. Moonpreneur builds that foundation. shorturl.at/L3YoV #Moonpreneur #STEMKids
🚀 Robotics: LEGO® & Vexplorers Summer Camp (Ages 9–11) 📍 Riverside / Temecula 🎯 Limited spots – enroll now! #STEMKids #RoboticsCamp #SummerCamp #CodingForKids #LEGOEducation #VEXRobotics #Temecula #Riverside #FutureEngineers

🧲🔬🧪Discover our 12 IN 1 Magnetic Educational Science Kit at The Little Tots Store! 🧬🧠 The ultimate STEM adventure for curious minds! 🌈🏫🚀 🎟️ Code: springin26 (20% OFF!) 💸 $35.88 💻thelittletotsstore.com/.../12-in-1-ma… #TheLittleTotsStore #STEMKids #ScienceFun #SpringSale #TBThursday

MatataStudio partners with ALLNET as the exclusive distributor in Germany for 2026, covering both robotics and digital microscope product lines! 🤖 Together, we look forward to expanding hands-on STEM learning across the region. 🇩🇪 #MatataStudio #STEMeducation #STEMkids #STEAM

3.14159265359...Celebrate the unending fun of #PiDay with a simple yet mind-boggling craft for the kiddos! pbs.org/parents/crafts… Get them looping around pi with this tasty little activity. 🥧👩🔬👨🔬 #MathCrafts #STEMKids

Impressive concentration at our Prep STEM Club last night! Look at these amazing white blood cell drawings under the microscope! 🧬✨ #STEMKids #FutureScientists #MicroscopyMagic #LearningThroughPlay

The Silver @CRESTAwards challenges your 14+ year-olds to run their own STEM projects in teams or individually! Find out more about Silver awards and projects to inspire them here: crestawards.org/crest-silver #STEMKids #STEMActivities

Roller coaster day! 🎢 Students learned about gravity & energy, then designed and built their own creative paper roller coasters. #STEMKids #EngineeringFun #FutureEngineers



#STEMThursday returns with reading picks for our little builders, engineers and coders! Sample these wonderful books in paired reading in your next STEM classroom activity. #STEMKids #ScienceEducation #CodingJourney

In celebration of yesterday’s #nationalstemday, here are some pics from last week’s Saturday STEM Academy session. Take look at our future STEM leaders! 👩🏻🔬 🔬 #SSA #stemkids




Jordan’s favorite Crunch Lab creation to date? A Dynamo Disco Ball! 🪩⚡ Imagine Blu and D.O.G. turning any room into a high-energy dance party—because science should be FUN! What would you invent? #RainingRobots #CrunchLab #STEMkids


Big thanks to @lab_tots for sparking young minds and kicking off #ScienceWeek with a bang! 🚀🔬 Your commitment to inspiring curiosity in our little scientists is truly commendable. Here's to a week filled with wonder, exploration, and endless possibilities! 🌟 #STEMKids




Day 2 - The British Motor Show in Farnborough and these two were very impressed by the BYD Atto 3. Mum messaged since saying this car was the highlight of their day which says A LOT for these car lovers 🚗 #future #STEMkids #electriccar @UKmotorshow @WOMACtweets @BYDCompany

We'll be open for the 10 am and 1 pm sessions only. Visit childsci.org/plan-your-visi… and save $2 per ticket. #WinterWonderLab #STEMKids #HandsOnScience #ChildrensMuseum #FairOaksMall #NorthernVA #NOVA #SchoolHoliday #KidsActivities #SnowDayFun less

Lights + Legos = STEM magic at Fort Tryon JCC! 🤖✨ Students coded blinking lights, built Lego vehicles, and leveled up their word block programming skills. So proud of their creativity and growth! 💡💻💕 #STEMkids #CodingForKids #FutureInnovators #HandsOnLearning #LEGO #STEM



Check out our #spring news and holiday events Read 🔎 ow.ly/XOMh50N6Xy6 Science Oxford Holiday Clubs 🌱 Nature Club 🐾 STEM Clubs 💥 Family Days & Sensory-friendly Day 🎒 Water Lab open 🌊 🖋️ Family science @oxfordlitfest 🐞 #WorldBookDay competition #STEMkids

Read about what I do on May 4th by clicking the link below!! misstechqueen.com/2022/04/22/sta… #stem #iteachstem #stemkids #education #edtech #iteach #techtips #techteacher #computerclass #googleforkids #steamteacher #teacherinspo #tpt #teacherlife #steam #teachersoftpt #stemteacher

Turn learning into play! 🧩🕹️ Try puzzle solving, pattern games, and story sequencing to introduce computational thinking concepts to your little ones. It's fun and educational! #ParentingTips #EarlyEducation #STEMKids"

Participate at the Yucca Valley Community Center on Saturdays, Sept 27 – Oct 18, from 9:30–10:30 a.m. 💲 $25 per class 👉 Register now at secure.rec1.com/CA/yucca-valle… or call (760) 369-7211 #YuccaValley #STEMKids #ScienceClass

Builders, join us for a #LEGO challenge! Bring your imagination and we’ll supply the LEGOs and challenges. Register at buff.ly/3U4ZnHF. #STEM #STEMKids #KidsActivities #Libraries

Sasa Nairobi, Science around me is back this midterm break! Let's catch kids young and curious, our theme this month is exploring space! Guess what? We have a free session this Saturday. Book a slot bit.ly/ScienceAroundMe #stemkids #nairobikids

Cyber fun with Junior Girl Scout Cybersecurity Badge🚀🖥️ Learning to stay safe online & think like tech heroes 💡 Join us: [email protected] #GirlScouts #Cybersecurity #STEMKids #TeenPSA


Preschool fall STEM with pumpkins and leaves! preschooltoolkit.com/blog/fall-pump… #fallactivities #stemkids #prekactivities

Our favourite engineer Simon swung by today to show us what he does when he designs water mains, sewers and roads. So of course we had to design our own!!! #STEMkids



Something went wrong.
Something went wrong.
United States Trends
- 1. #WWERaw N/A
- 2. Brandon Ingram N/A
- 3. Ethan Page N/A
- 4. #RawAfterMania N/A
- 5. Sol Ruca N/A
- 6. Thune N/A
- 7. Porter Martone N/A
- 8. Tim Cook N/A
- 9. Jalen Johnson N/A
- 10. Pens N/A
- 11. Tippett N/A
- 12. Mitchell Robinson N/A
- 13. #IgniteTheOrange N/A
- 14. Penguins N/A
- 15. Mike Brown N/A
- 16. #AmericanIdol N/A
- 17. Letang N/A
- 18. All Ego N/A
- 19. Malkin N/A
- 20. #Flyers N/A












































































